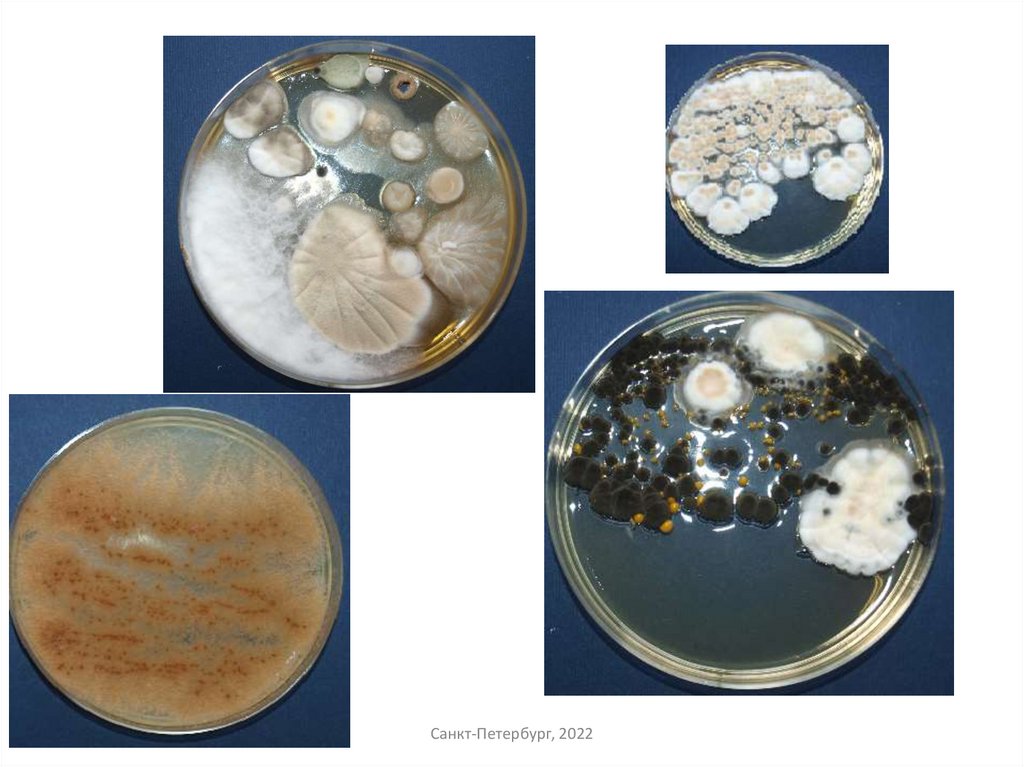

Похожие презентации:
Лекция3_Мицелиальные грибы
1. ТЕМА: Морфология мицелиальных грибов
Разработал: доц. Белокурова Е.С.Санкт-Петербург, 2022
2. ГРИБЫ (mycota или fungi)
Грибы являются низшими растениями, хлорофилла не имеют и поэтомуони не способны синтезировать органические вещества из углекислого газа, как
зелёные растения. Для роста и развития грибов им необходимы готовые
органические вещества. В природе грибы обитают на разных субстратах: в воде,
почве, на растениях и животных. Чаще всего грибы развиваются на поверхности
субстрата, образуя паутиновидные сплетения, многие из них называют
плесенями. Многие грибы имеют промышленное значение и используются для
получения ферментных препаратов, органических кислот, антибиотиков.
Многие грибы вызывают порчу пищевых продуктов и некоторых
товаров, а также заболевания растений, человека и животных. Некоторые грибы
способны вырабатывать токсичные для человека вещества- микотоксины.
Существуют грибы, которые поражают культурные растения в процессе
их вегетации, нанося большой урон сельскому хозяйству, имеются грибы,
патогенные для человека и животных.
Санкт-Петербург, 2022
3. Строение грибов
Тело гриба называется грибницей, или мицелием. Оно состоит изтонких, сильно разветвлённых нитей - гиф, переплетённых в виде войлока.
Клетки мицелия имеют оболочку, протоплазму с различными включениями, ядра
и ядрышки. От мицелия поднимаются воздушные гифы. Чаще всего грибы
являются многоклеточными организмами и видны невооружённым глазом. В этом
случае гифы их разделены перегородками на отдельные участки ( септированы).
Грибы с несептированными гифами являются одноклеточными. У этих грибов
весь мицелий представляет собой как бы одну гигантскую клетку с большим
числом ядер.
Толщина гиф разнообразна, размер их поперечника колеблется от 5 до
15 мкм и более, гифы растут вершиной или концами разветвлений в питательной
среде и на её поверхности. Из плотного переплетения гиф образуются плодовые
тела с органами размножения - особыми гифами со спорами, которые
поднимаются над субстратом.
Санкт-Петербург, 2022
4. Строение мицелия грибов
Одноклеточный(несептированный)
Многоклеточный
(септированный)
Санкт-Петербург, 2022
5. Отличия грибов от растений
Грибы имеют эукариотный тип клетки, строение её сходно с клетками другихрастительных организмов, но у грибов отсутствуют пластиды.
Пластиды — органоиды, специфичные для клеток растений (они имеются в
клетках всех растений, за исключением большинства бактерий, грибов и
некоторых водорослей).
Различают 3 вида пластид:
Бесцветные пластиды — лейкопласты;
окрашенные — хлоропласты (зеленого цвета);
окрашенные — хромопласты (желтого, красного и других цветов).
Клетки большинства грибов имеют многослойную клеточную стенку, состоящую
на 80-90% из полисахаридов, в небольшом количестве имеются белки, липиды,
полифосфаты. Основным полисахаридом у клеточной стенки большинства
грибов является хитин, у некоторых целлюлоза.
Санкт-Петербург, 2022
6. Размножение грибов
Отличительной особенностью грибов является большое разнообразие у нихспособов и органов размножения. Один и тот же гриб часто имеет несколько
форм размножения. При этом гриб может настолько менять свою внешнюю
форму, что в каждой из них его рассматривают как самостоятельный вид.
Грибы размножаются вегетативным, бесполым и половым путями.
Вегетативное размножение
происходит
без образования
каких-либо
специализированных органов: частями мицелия или отдельными клетками оидиями ( артроспорами), образующимися в результате расчленения гиф, которые
на питательном субстрате разрастаются в грибницу.
При бесполом и половом размножении образуются специализированные клетки споры, с помощью которых и осуществляется размножение.
Санкт-Петербург, 2022
7. Бесполое размножение При бесполом способе размножения споры образуются на особых гифах воздушного мицелия, внешне отличающихся
от других гиф.У одних грибов споры образуются эндогенно внутри особых клеток, развивающихся на концах
гиф. Эти клетки - вместилища спор называют
спорангиями, находящиеся в них споры спорангиоспорами, а гифы, несущие спорангии
со спорами - спорангиеносцами.
У других грибов споры образуются экзогенно
(открыто) - на вершине гиф, снаружи их. Такие
споры называются конидиями, а гифы, несущие
их конидиеносцами.
Санкт-Петербург, 2022
8. Половое размножение грибов
При половом размножении грибов спорообразованиюпредшествует половой процесс - слияние половых клеток с
последующим объединением их ядер. При этом сливаются
две клетки, дифференцированные в половом отношении и
имеющие в ядре одинарный набор хромосом - гаплоидные
клетки. После слияния образуется клетка с двойным набором
хромосом - диплоидная. В результате чего формируются
специализированные органы размножения. Развитие этих
органов, формы полового процесса у грибов разнообразны.
У грибов с клеточным мицелием в качестве органа полового
размножения образуются базидии со спорами или сумки со
спорами.
Санкт-Петербург, 2022
9. Классификация грибов
В основу систематики грибов положены следующие основныепризнаки: строение мицелия, типы полового и бесполого размножения.
Основными классами грибов являются:
хитридиомицеты,
оомицеты,
зигомицеты,
аскомицеты,
базидиомицеты,
дейтеромицеты (несовершенные грибы)
Большинство грибов может размножаться бесполым и половым путём,
такие грибы называют совершенными. Некоторые грибы неспособны к половому
размножению, их называют несовершенными.
Санкт-Петербург, 2022
10. СПЕЦИФИЧЕСКИЕ ОСОБЕННОСТИ ДРОЖЖЕЙ
Дрожжи - одноклеточные грибы, не образующие мицелия, относящиесяк классу сумчатых грибов - аскомицетов. Типичным способом вегетативного
размножения является почкование. Деление клеток встречается редко. В природе
дрожжи встречаются всюду, где есть сахаросодержащие жидкости, - в нектаре
цветов, на плодах и ягодах, листьях растений, в почве садов и виноградников.
Дрожжи имеют огромное значение в пищевой промышленности
благодаря способности превращать сахар в спирт и углекислоту. За эту
особенность их часто называют сахарными грибами или сахаромицетами.
С другой стороны, развитие дрожжей в пищевых продуктах вызывает их
порчу (вспучивание, изменение запаха и вкуса).
Форма и размеры дрожжей могут заметно изменяться в зависимости от
условий развития, а также от возраста клеток. Чаще встречаются дрожжи
округлой формы или эллиптической. Размеры дрожжевых клеток не превышают
10-15 мкм.
Санкт-Петербург, 2022
11. Виды дрожжей
По использованию впромышленности
Хлебопекарные
Винные
Пивные
Спиртовые
Для сидра
По агрегатному состоянию
• Жидкие
• Прессованные
• Сушёные
Санкт-Петербург, 2022
12. Размножение дрожжей
• Вегетативное (почкованием)• Бесполое (с помощью спор)
• Половое
Санкт-Петербург, 2022

Биология
Биология








